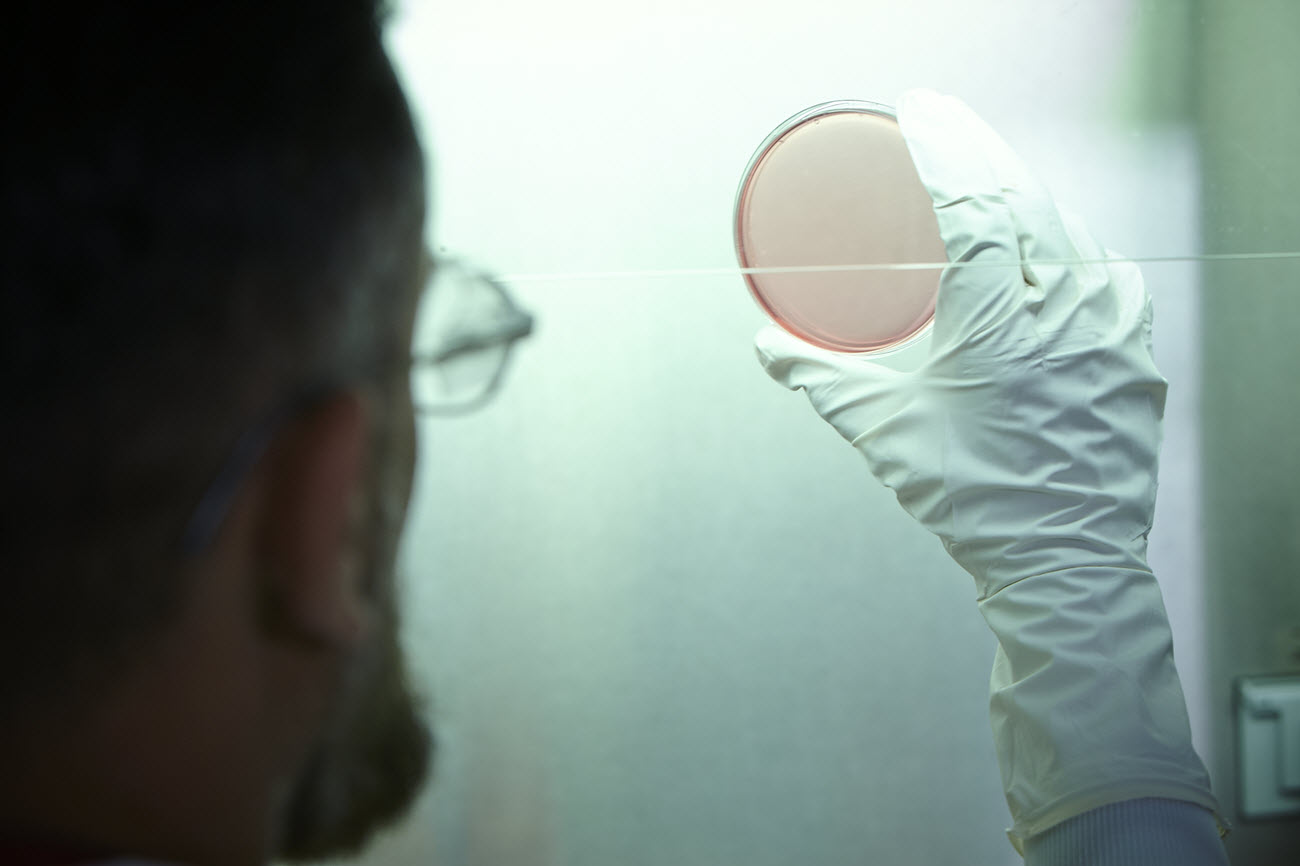

Rise of the Superbugs: 5 Key Questions Answered

Antimicrobial resistance (AMR) is undermining one of the foundations of our healthcare systems – antibiotics. The impact could be as large or even larger than COVID-19, in terms of deaths and economic costs 1. Here we tell you what you need to know about the AMR threat.
1. Why should I care about antibiotics?
For almost 100 years we have relied on antibiotics to treat bacterial infections and help reduce the spread of infection throughout a community.
It’s easy to forget that before the advent of mass-produced antibiotics in the 20th Century (penicillin being among the first and most famous), a simple infection could worsen and become life-threatening. Symptoms caused by bacteria – such as diarrhea – were not the inconvenience they are today; they were mass killers 2. Indeed the common story about Albert Alexander, the first human patient to be treated with injections of penicillin to treat an infection, is that he scratched his mouth on a thorn while pruning roses. The proof for this is in dispute though, and evidence suggests it’s more likely it was due to wartime injuries 3.

Antibiotics and antivirals changed all that.
Today they are used on health problems that are unlikely to clear up without treatment, ranging from commonplace problems like acne or ear infections, to potentially life-threatening conditions like pneumonia. They are also used to prevent infection or aid recovery after all sorts of medical procedures, from getting a tooth removed by a dentist, to complex treatments like organ transplants or chemotherapy.
They are a cornerstone of modern medicine.
2. So what’s the problem?
The efficacy that antibiotics and antivirals offer – and which we often take for granted – is at risk. ‘Superbugs’ are emerging – bacteria that become resistant to antibiotics. This makes it harder to treat infections and increases the risk of disease spread among people and in our global food supply, leading to illness and death.
The statistics on the spread of superbugs are stark. In the US alone, 35,000 people die each year as a result of drug-resistant infections. Globally, these infections kill 700,000 people each year, including 230,000 from multidrug-resistant tuberculosis. If no action is taken, the World Health Organization (WHO) estimates this total could increase to 10 million deaths each year by 2050 4.
Arguably the most powerful tool in healthcare is under threat. We are all at risk from this phenomenon. And we may not have the right medicines to fight it.
3. Why is this happening?
Inadequate access, overuse and misuse of antimicrobials, which include antibiotics, antiviral therapies and medicines to treat parasitic infections and fungal diseases, lie at the heart of AMR 5.
One factor is the over and improper use of antibiotics to treat illnesses in patients. Antibiotics can be prescribed unnecessarily meaning the patient's illness did not require treatment with an antibiotic while shortages of antimicrobials can mean doctors resort to using inferior treatments to treat patients, which increases AMR risk. Another factor is the inappropriate use of antibiotics, for example in treating non-bacterial diseases.

The inappropriate or over-use of antibiotics in animal agriculture, for example to encourage growth and compensate for the unsanitary conditions some animals live in, is also a contributing factor to AMR 6.
These factors have helped bacteria to evolve and some have become resistant to antibiotics, rendering these medicines ineffective in treating some infections. At the same time, there aren’t enough antibiotics in development to counter these new superbugs.
4. Why isn’t the pharmaceutical industry just making new antibiotics?
Despite the urgent need for new antibiotics, there is limited funding for their development.
Developing antibiotics is a complex and uncertain process that can take years. Many treatments in development fail along the way. As such, it can be difficult for developers – particularly smaller biotech companies developing new antibiotics – to get financing for clinical development.

Even if they do get the drug over the line, they may never recoup the investment because antibiotics are often used sparingly to preserve effectiveness. There are numerous examples of antibiotic-focused biotechs that have declared bankruptcy or given up on antibiotics, due to the lack of commercial sustainability.
This makes the situation even worse as the sector loses valuable expertise and resources.
5. What is Teva doing to sort this out?
Combatting AMR takes an international, coordinated approach that brings together the life sciences industry, health associations and regulators.
As one of the world’s largest manufacturers of antibiotics and their active ingredients, Teva has a big part to play in this. We manufacture 83% of antibiotics/anti-infectives on the WHO’s Essential Medicine List 7 and reach 200m patients every day. As such, we are acutely aware of the threat and at the forefront of raising awareness and looking for solutions.
We are working with industry peers and global health organizations to identify solutions that protect people and provide new ways to reduce AMR. These activities include:
- We serve on the board of the AMR Industry Alliance, where 100+ biotech, diagnostic, generic and research-based pharmaceutical companies have joined forces to drive progress in reducing AMR. (We are also helping to develop and improve the Alliance’s Common Manufacturing Framework, as well as its Antibiotic Discharge Targets.)
- We joined 20+ other pharmaceutical companies in launching the $1bn AMR Action Fund, which aims to support biotech companies in developing two to four new antibiotics for patients by 2030.
- We are committed to supporting mechanisms to ensure affordable access to new and existing antibiotics for people who need them, in all parts of the world and at all levels of income. To date, Teva has developed more than 35 generic antibiotics and antifungals, more than 20 of which target World Health Organization priority pathogens.
- We are ranked by independent monitors, such as Access to Medicine Foundation’s (ATMF) AMR benchmark. This offers an independent comparison of pharmaceutical companies’ efforts to bring AMR under control. (Our score on that benchmark rose by 37% in 2020, putting us in second place among generics manufacturers). We’re also happy to say our efforts to avoid use of sales agents to cut the risk of overselling were recognized as benchmark best practice.
- We are committed to the responsible production of antimicrobial compounds and minimizing their discharge to the environment from our 61 manufacturing facilities around the world. Our strict supplier code of conduct means factories in our extended supply chain are subject to strict environmental rules if they want to work with us.
Do your bit to fight AMR
You can help ensure proper use of antibiotics by:
|
NPS-ALL-NP-00719 OCTOBER 2022
Find out more
- Find out more about our $1bn AMR Action Fund
- Read Teva’s Position on Antimicrobial Resistance
- Download tips and recommendations for proper use of antibiotics
- Read about Teva’s progress in its wider Environmental, Social, and Governance activities
Footnotes
[1] https://amractionfund.com/amr-innovation-challenge/#page-section-0
[3] https://www.ox.ac.uk/news/science-blog/75-years-penicillin-people
[5] https://www.who.int/news-room/fact-sheets/detail/antimicrobial-resistance
[6] Time Magazine. ‘Which foods are treated with anitbiotics?’ October 2016.
[7] Source: Teva 2021 Environmental, Social and Governance Progress Report
[8] Centers for Disease Control and Prevention. Appropriate Antibiotic Use: Community; What You Can Do. 2018. Available: https://www.cdc.gov/antibiotic-use/community/about/can-do.html (accessed October 2022).
[9] US Food and Drug Administration. Combating Antibiotic Resistance. 2018.
Available: https://www.fda.gov/ForConsumers/ConsumerUpdates/ucm092810.htm (accessed October 2022).
[10] Centers for Disease Control and Prevention. Appropriate Antibiotic Use: Community; What You Can Do. 2018. Available: https://www.cdc.gov/antibiotic-use/community/about/can-do.html (accessed October 2022).
[11] World Health Organization. Everyone Has a Role to Play Infographic. 2017. Available: https://www.paho.org/en/documents/world-antibiotic-awareness-week-2017-infographic-everyone-has-role-play-pdf (accessed October 2022).
[12] World Health Organization. Everyone Has a Role to Play Infographic. 2017. Available: https://www.paho.org/en/documents/world-antibiotic-awareness-week-2017-infographic-everyone-has-role-play-pdf (accessed October 2022).








